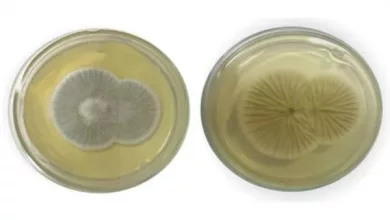

Saúde
-

Fiocruz anuncia parceria tecnológica para produção de mosquitos antidengue no Brasil
A Fundação Oswaldo Cruz (Fiocruz) e o World Mosquito Program (WMP) anunciaram, nesta quinta-feira (30), uma parceria tecnológica para aumentar…
Leia mais » -

Preços dos remédios sobem 5,6% a partir deste sábado
Os preços dos remédios sobem 5,6% a partir deste sábado (1º), atendendo a definição da Câmara de Regulação do Mercado…
Leia mais » -

Policlínica de São Francisco do Conde abre inscrição para contratação de profissionais
Estão abertas até o próximo dia 02 de abril as inscrições para o Processo Seletivo Simplificado para contratação, em caráter…
Leia mais » -

Casos de dengue grave neste ano já são mais da metade de 2022
Os casos de dengue grave na Bahia nos três primeiros meses deste ano já correspondem a mais da metade (55%)…
Leia mais » -

Justiça obriga plano de saúde a fornecer medicamento canabidiol a criança com paralisia em Mutuípe
A Quarta Câmara Cível do Tribunal de Justiça da Bahia (TJ-BA) negou recurso interposto pela Sulamérica Companhia Seguro Saúde e…
Leia mais » -

Menos de 300 mil baianos tomaram a vacina bivalente contra a Covid-19
Menos de 300 mil baianos compareceram aos postos de vacinação para tomar a vacina bivalente contra a Covid-19. O número aponta…
Leia mais » -

Anvisa aprova tratamento com injeção semanal contra obesidade
A Agência Nacional de Vigilância Sanitária (Anvisa) aprovou na última segunda-feira (2), o primeiro tratamento semanal para obesidade no Brasil.…
Leia mais » -
Fiocruz registra 1º caso de meningoencefalite por fungo raro no Brasil
Cientistas do Instituto Oswaldo Cruz (IOC/Fiocruz) registraram o primeiro caso de meningoencefalite causada pelo fungo Penicillium chrysogenum no Brasil. Uma adolescente de…
Leia mais » -

Para 42% dos brasileiros, saúde deve ser prioridade de Lula
Para 42% dos brasileiros, saúde é a área que precisa receber mais atenção e ser prioridade do presidente eleito Luiz…
Leia mais » -

Para ampliar cobertura, OMS muda recomendação da vacina contra HPV
A Organização Mundial da Saúde (OMS) atualizou as recomendações para a vacinação contra o HPV. O imunizante agora pode ser aplicado em dose única,…
Leia mais »

